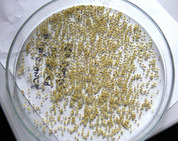

Schwerpunkt Pflanzentechnologie
Warum Pflanzentechnologie?
Warum Pflanzentechnologie?
Die Biologie der Pflanzen birgt noch immer viele Geheimnisse. Diese zu lösen ist nicht nur eine spannende Aufgabe, sondern auch der Schlüssel zur Lösung vieler globaler Herausforderungen. Ertragsreiche und gesunde Kulturpflanzen stellen sicher, dass die wachsende Weltbevölkerung mit ausreichend Nahrung versorgt werden kann. Zudem liefern Pflanzen nachwachsende und auch neuartige Rohstoffe für die Industrie. Beim Aufbau ihrer Biomasse fixieren Pflanzen CO2 und wirken so einer ansteigenden Konzentration dieses Treibhausgases in unserer Atmosphäre entgegen. Pflanzen bereiten damit die Grundlage für nachhaltige Produktionsprozesse in unserer Wirtschaft.
Um das Potenzial von Pflanzen für die vielfältigen Nutzungsformen durch den Menschen zukünftig noch besser erschließen zu können, muss man das Zusammenspiel von Erbanlagen und Umwelteinflüssen genau verstehen. Daran arbeiten weltweit viele Wissenschaftlerinnen und Wissenschaftler. Sie versuchen z. B. herauszufinden, wie Ernteerträge im Zuge des Klimawandels auch bei längeren Hitzeperioden und vermehrter Trockenheit gesichert werden können. Andere Forschergruppen verfolgen das Ziel, Pflanzen zu züchten, die sich selbst gegen Schädlinge wehren können, ohne mit chemischen Pflanzenschutzmitteln behandelt zu werden.
Im Schwerpunkt Pflanzentechnologie des Studiengangs Angewandte Pflanzenbiologie erhältst Du aufbauend auf den Grundlagen der Botanik einen umfassenden Einblick in die Erforschung von Kulturpflanzen und kannst Dich praxisnah auf vielfältige Berufsfelder in dieser grünen Wachstumsbranche vorbereiten.
Du willst genauer wissen, welche Möglichkeiten und Perspektiven in der Pflanzentechnologie liegen? Dann kannst Du Dich hier noch weiter informieren:
Pflanzen prägen unsere Umwelt maßgeblich und sind zugleich als nachwachsender Rohstoff ein bedeutender Wirtschaftsfaktor. Sie stehen am Anfang einer langen Wertschöpfungskette. Aus Pflanzen werden heute nicht nur Nahrungs- und Futtermittel, sondern viele weitere Produkte wie z. B. Arzneimittel, Farbstoffe, Verpackungsmaterialien und Biokraftstoffe hergestellt. Da die Vorräte an fossilen Ressourcen wie Erdöl schwinden und somit nur noch begrenzte Zeit als Energieträger und Rohstoffe für Materialien wie z. B. Kunststoffe zur Verfügung stehen, gewinnen Pflanzen auch in diesen Feldern zunehmend an Bedeutung.
Um den weltweit steigenden Bedarf an pflanzlichen Erzeugnissen zu decken, sind große Anstrengungen erforderlich. Die Anbauflächen können kaum noch erweitert werden. Daher gilt es, die Effizienz der Pflanzenproduktion zu steigern, also mehr Ertrag auf den zur Verfügung stehenden Flächen zu erzielen. Hierfür sind innovative, nachhaltige Anbauverfahren erforderlich, um die Umwelt so wenig wie möglich zu belasten. Eine Schlüsselrolle spielt in diesem Zusammenhang die Züchtung neuer Pflanzensorten, welche z. B. besser an salzige Böden, den Klimawandel oder Schädlingsbefall angepasst sind. Aber auch innovative Pflanzenschutzstrategien, beispielweise durch den Einsatz von Nützlingen, und eine bedarfsgerechte Nährstoffversorgung der Kulturpflanzen können zur Lösung dieser Herausforderungen wichtige Beiträge leisten.
Im Schwerpunkt Pflanzentechnologie des Studiengangs Angewandte Pflanzenbiologie befasstDich ausführlich mit den großen Zukunftsaufgaben in der Züchtung und Produktion von Kulturpflanzen. Natürlich zeigen wir Dir auch, welche Verfahren und Techniken schon heute für eine umweltschonende Erzeugung von qualitativ hochwertigen Pflanzen zur Verfügung stehen.
Aufbauend auf naturwissenschaftlichen und botanischen Grundlagen werden im Studium alle wichtigen Wachstumsfaktoren zur Steuerung der Produktion von Kulturpflanzen behandelt. Aspekte der Pflanzenernährung und des Pflanzenschutzes werden dabei besonders vertieft. Ferner lernst Du die Methoden der modernen Pflanzenzüchtung und Saatguterzeugung kennen. Begleitend hierzu erwirbst Du Kenntnisse in molekularbiologischen und biochemischen Analyseverfahren, in der Versuchstechnik sowie in statistischen Verfahren zur Auswertung von pflanzenbaulichen Untersuchungen.
Das Studium richtet sich an junge Menschen mit einer Hochschulzugangsberechtigung, die Interesse an der Biologie von Pflanzen haben. Wenn Du also z. B. einen Bio-Leistungskurs in der Oberstufe belegt hast und ein Biologiestudium mit hohem Anwendungsbezug sowie ausgezeichneten Berufsperspektiven suchst, dann solltest Du dieses Studienangebot genauer unter die Lupe nehmen. Ebenso sind Studieninteressierte angesprochen, die bereits über eine praktische Ausbildung z. B. als Pflanzentechnologin bzw. -technologe, Biologielaborantin bzw. -laborant, Gärtnerin bzw. Gärtner oder Landwirtin bzw. Landwirt verfügen und nun den nächsten Schritt in ihrer beruflichen Karriere anstreben.
Absolventinnen und Absolventen der Studienvertiefung Pflanzentechnologie eröffnen sich vielfältige, interessante Berufsperspektiven, z. B. in der Pflanzenzüchtung und Saatgutproduktion, in der Pflanzenschutz-, Dünge- und Gewässerschutzberatung sowie in pflanzenbaulichen Forschungs- und Versuchseinrichtungen (Beruf & Karriere). Zur Weiterqualifikation für Führungspositionen in Industrie und Forschung können ein Masterstudium und dann noch eine Promotion angeschlossen werden.